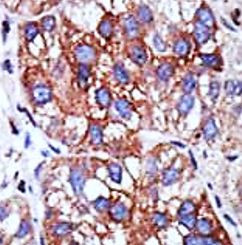
Anti-YY1

Cookie preferences
This website uses cookies, which are necessary for the technical operation of the website and are always set. Other cookies, which increase the comfort when using this website, are used for direct advertising or to facilitate interaction with other websites and social networks, are only set with your consent.
Configuration
Technically required
These cookies are necessary for the basic functions of the shop.
"Allow all cookies" cookie
"Decline all cookies" cookie
CSRF token
Cookie preferences
Currency change
Customer-specific caching
FACT-Finder tracking
Individual prices
Selected shop
Session
Comfort functions
These cookies are used to make the shopping experience even more appealing, for example for the recognition of the visitor.
Note
Show the facebook fanpage in the right blod sidebar
Statistics & Tracking
Affiliate program
Conversion and usertracking via Google Tag Manager
Track device being used
| Item number | Size | Datasheet | Manual | SDS | Delivery time | Quantity | Price |
|---|---|---|---|---|---|---|---|
| ARG55023.100 | 100 µl | - | - |
6 - 14 business days* |
616.00€
|
If you have any questions, please use our Contact Form.
You can also order by e-mail: info@biomol.com
Larger quantity required? Request bulk
You can also order by e-mail: info@biomol.com
Larger quantity required? Request bulk
Protein function: Multifunctional transcription factor that exhibits positive and negative... more
Product information "Anti-YY1"
Protein function: Multifunctional transcription factor that exhibits positive and negative control on a large number of cellular and viral genes by binding to sites overlapping the transcription start site. Binds to the consensus sequence 5'-CCGCCATNTT-3', some genes have been shown to contain a longer binding motif allowing enhanced binding, the initial CG dinucleotide can be methylated greatly reducing the binding affinity. The effect on transcription regulation is depending upon the context in which it binds and diverse mechanisms of action include direct activation or repression, indirect activation or repression via cofactor recruitment, or activation or repression by disruption of binding sites or conformational DNA changes. Its activity is regulated by transcription factors and cytoplasmic proteins that have been shown to abrogate or completely inhibit YY1-mediated activation or repression. For example, it acts as a repressor in absence of adenovirus E1A protein but as an activator in its presence. Acts synergistically with the SMAD1 and SMAD4 in bone morphogenetic protein (BMP)-mediated cardiac-specific gene expression (PubMed:15329343). Binds to SMAD binding elements (SBEs) (5'- GTCT/AGAC-3') within BMP response element (BMPRE) of cardiac activating regions. May play an important role in development and differentiation. Proposed to recruit the PRC2/EED-EZH2 complex to target genes that are transcriptional repressed. Involved in DNA repair. In vitro, binds to DNA recombination intermediate structures (Holliday junctions). Plays a role in regulating enhancer activation (PubMed:28575647). [The UniProt Consortium]
| Keywords: | Anti-YY1, Anti-YY-1, Anti-NF-E1, Anti-INO80S, Anti-Yin and yang 1, Anti-INO80 complex subunit S, Anti-Delta transcription factor, Anti-Transcriptional repressor protein YY1 |
| Supplier: | Arigo Biolaboratories |
| Supplier-Nr: | ARG55023 |
Properties
| Application: | IHC (paraffin), WB |
| Antibody Type: | Polyclonal |
| Conjugate: | No |
| Host: | Rabbit |
| Species reactivity: | human (Expected: mouse) |
| Immunogen: | KLH-conjugated synthetic peptide corresponding to aa. 74-104 (N-terminus) of Human YY1 |
| Format: | Purified |
Database Information
| KEGG ID : | K09201 | Matching products |
| UniProt ID : | P25490 | Matching products |
| Gene ID : | GeneID 7528 | Matching products |
Handling & Safety
| Storage: | -20°C |
| Shipping: | +4°C (International: °C) |
Caution
Our products are for laboratory research use only: Not for administration to humans!
Our products are for laboratory research use only: Not for administration to humans!
Information about the product reference will follow.
more
You will get a certificate here
Viewed